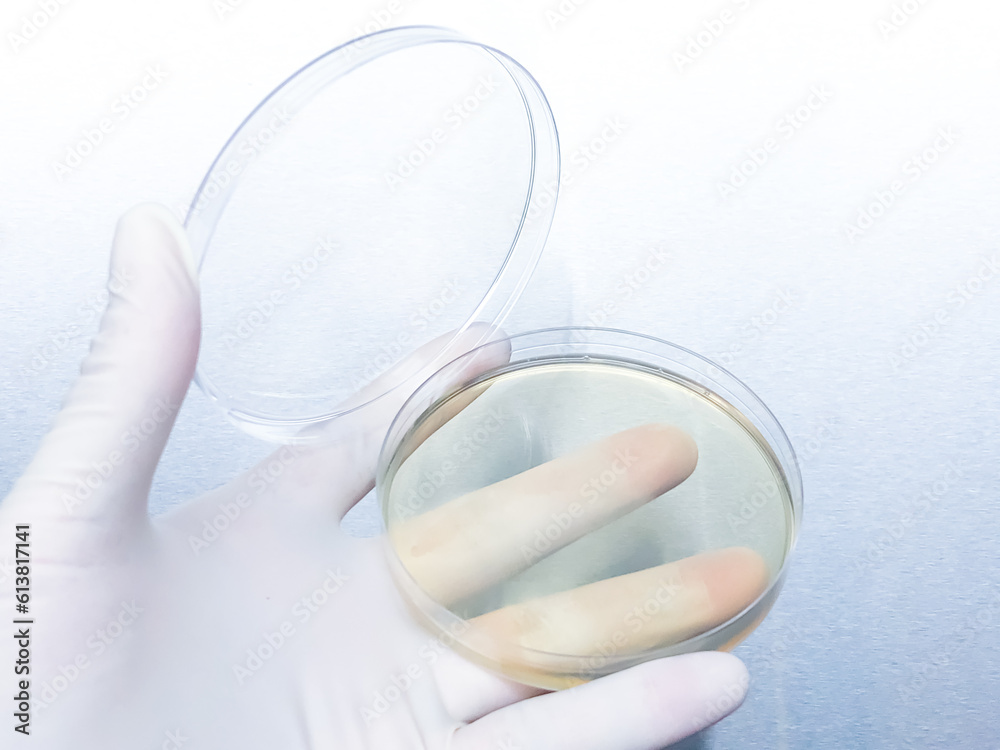
Microbial experimenters are conducting experiments in modern laboratory.

Votre panier est vide!
LIVRAISON GRATUITE PARTOUT | 30% De Réduction Sur Tout Le Site !
LIVRAISON GRATUITE |
DEVENIR DÉTAILLANT
| CALCULATEUR DE PRIX
LIVRAISON GRATUITE PARTOUT | 30% De Réduction Sur Tout Le Site !
LIVRAISON GRATUITE |
DEVENIR DÉTAILLANT
| CALCULATEUR DE PRIX
about
CALCULATEUR DE PRIX
- ×
-
Voir les catégories d'images
Il est important d'ajouter 2 pouces de matériel supplémentaire en largeur et en hauteur pour faciliter l'installation lors du recouvrement d'un mur complet. Pour une couverture partielle du mur, entrez des mesures précises.
Microbial experimenters are conducting experiments in modern laboratory.
Code produit:
613817141
La ou les dimensions que vous avez saisies sont inférieures à 24 ".
Êtes-vous sûr d'avoir saisi les mesures correctes?
Taille maximale
Vous n'avez pas entré les mesures correctes pour Canvas.
Veuillez d'abord télécharger votre image personnalisée
Veuillez d'abord télécharger votre image personnalisée
Vous trouverez ci-dessous les spécifications requises pour annexer les détails du produit à un projet.
Pour plus d'informations, veuillez contacter : [email protected] - 1-888-515-5177.
| Spécifications du produit | Détails |
|---|---|
| Code produit | DECO- 613817141 |
| Quantité | 1 |
| Largeur du mur (Pouces) | |
| Hauteur du mur (Pouces) | |
| Catégorie | |
| Retourner l'image | |
| Matériel | |
| Description Matériel | |
| Transformer(Cropper) | |
| Product Image |
Information produit
| Matériel | |
| T1000 Toile de canevas | Toile d’artiste texturée. Peut être utilisé comme murales lorsqu’il est appliqué sur le mur avec un adhésif mural ou étiré autour d’un cadre en bois pour accrocher sur un mur. |
| Decomurale DR2000-GF | Média de revêtement mural en vinyle imprimé de qualité commerciale avec couleur dorée brilliante. - Lisse,brillant et réfléchissant. - Souvent rehaussé d’encres blanches ou autres encres opaques. - Aucune texture, surface lisse, haute brillance. - A une surface dorée. |
| Decomurale DR2000-BLG | Média de revêtement mural en vinyle imprimé de qualité commerciale avec perles texturées qui brillent de minuscules particules d’argent. - Simule l’apparence de petites perles de verre. - Peut ajouter une brillance métallique aux couleurs. - Texture lourde, surface rugueuse, effet scintillant variable. - A un aspect gris clair en raison du revêtement brillant argenté. |
| Decomurale DR2000-CF | Média de revêtement mural en vinyle imprimé de qualité commerciale avec couleur cuivre réfléchissant et marques verticales super fines. - Brillant et réfléchissant. - Souvent rehaussé d’encres blanches ou autres encres opaques. - Aucune texture, surface lisse avec marques vertical super fines, haute brillance. - Aune surface de couleur cuivre. |
| Decomurale DR2000-PL | Média de revêtement mural en vinyle imprimé de qualité commerciale avec couleur argent et une texture embossé. |
| Decomurale DR2000-BF | Média de revêtement mural en vinyle imprimé de qualité commerciale avec couleur noir lustré. - Lisse,brillant et réfléchissant. - Souvent rehaussé d’encres blanches ou autres encres opaques. - Aucune texture, surface lisse, haute brillance. - A une surface noir lustré. |
| Decomurale DR2000-SP | Média de revêtement mural en vinyle imprimé de qualité commerciale avec couleur perle réfléchissant et texture d’acier inoxydable super fine. - Combine une surface en relief unique avec un revêtement de perle exclusive. - Le résultat est un éclat plus discret, mais très sophistiqué et luxueux. - Ressemble à du tissu - mais il s’agit en fait d’un vinyle commercial entièrement fonctionnel. - Texture légère, surface lisse, haute brillance. La couleur de base du film est perle. |
| Decomurale DR2000-SO | Média de revêtement mural en vinyle imprimé de qualité commerciale avec couleur argent texturé et réfléchissant. - Texturé,brillant et réfléchissant. - Souvent rehaussé d’encres blanches ou autres encres opaques. - Aucune texture, surface lisse, haute brillance. - A une surface dorée. |
| Decomurale DR2000-SS | Média de revêtement mural en vinyle imprimé de qualité commerciale avec couleur gris argent réfléchissant et texture d’acier inoxydable super fine. - Combine une surface en relief unique avec un revêtement de perle exclusive. - Le résultat est un éclat plus discret, mais très sophistiqué et luxueux. - Ressemble à du tissu - mais il s’agit en fait d’un vinyle commercial entièrementfonctionnel. - Texture légère, surface lisse, haute brillance. - La couleur de base du film est un acier gris. |
| Decomurale SGF3000-LG | Film givré en vinyle pour applications sur verre. Imprimé avec des encres écologiques UV. Peut également être coupé à des fins de conception pour créer des lettres, des rayures, des motifs, des découpes et des contours. |
| Decomurale DR2000-PQ | Média de revêtement mural en vinyle imprimé de qualité commerciale. Décrit comme aspect tissu textile piqué, simule une couture de chemise habillée. |
| Decomurale DR2000-SK | Média de revêtement mural en vinyle imprimé de qualité commerciale. Décrit comme une texture de soie qui a de petites lignes horizontales dispersées au hazard. Surface adaptée à presque toutes les images. - Fournit juste assez de texture pour faire ressortir votre projet, sans interférer avec le design imprimé. - Texture légère en profondeur, surface lisse, faible brillance. - La texture crée une apparence convaincante de tissus de soie. |
| Tapisserie Textile- Qualité Commerciale 20 oz. | Tapisserie mural en vinyle 20 oz. de la plus haute qualité commerciale. La surface est adaptée pour toutes les images et fournit juste assez de texture pour faire ressortir votre projet, sans interférer avec le design imprimé. Non encollé. Colle à tapisserie requise. Joints invisible avec double coupe au mur. Un installateur professionnel est fortement recommander. Largeur de panneau entre 32 et 48 pouces. |
| Decomurale DR2000-AC | Média de revêtement mural en vinyle imprimé de qualité commerciale. Alternativement utilisé pour la reproduction numérique de la décoration murale de Giclee et Arts fines. - La texture est une reproduction de toile d’artiste.- Ajoute de l’élégance à n’importe quel mur. - Texture de profondeur moyenne, surface rugueuse, faible brillance. |
| Decomurale DR2000-CV | Média de revêtement mural en vinyle imprimé de qualité commerciale. Reproduit l’apparence de la texture tissée de toile utilitaire. A une apparence de tissu réaliste qui adoucit les détails et ajoute une dimension filetée rugueuse. - La texture est une reproduction de toile d’artiste. - Ajoute de l’élégance à n’importe quel mur. - Texture de profondeur moyenne, surface rugueuse, faible brillance. |
| Decomurale DR2000-CC | Média de revêtement mural en vinyle imprimé de qualité commerciale. Luxueux grain multidirectionnel. - Luxueux grain multidirectionnel. - Crée une réfraction de la lumière subtile et peut fournir de petits reflets de brillance. - Lorsqu’ils sont vus sous un angle. - Complimente presque tous les graphiques de conception. - Texture légère et profonde, surface rugueuse, faible brillance. |
| Decomurale SGC4000-L2 | Pellicule de polyester et optiquement clair avec résistance aux égratignures. Impression encres UV. |
| Matériel | |
| Vinyle Murale Autocollant - Panneau Chevaucher - Joints visibles | Vinyle épais avec adhésif sec et doublure arrière amovible - panneaux de 52 pouces de large. Application sèche. Finition mat. Joints superposés visibles. Résiste à l’humidité et à une exposition mineure à l’eau. Uniquement recommandé pour ceux qui ont besoin ou ont une préférence d’une méthode d’installation à sec. Papier peint recommandé pour qualité et fini supérieure. |
| Instructions Installation Vinyle Murale | |
| Papier Peint - Joints Invisible - Aucun panneau chevaucher | Papier peint intissé et préencollé - activé à l’eau - panneaux de 32 à 48 pouces de large (largeur maximale). Matériau épais sans joints superposés. Fini mat et feutré - Cache les imperfections mineures des murs. Installation facile et simple - laizes installés côtes à côtes - parfait pour les professionnels et les débutants. Aucune expérience requise. Résiste aux taches et résiste à l’humidité |
| Instructions Installation Papier Peint | |

Support
Pellicules pour vitrages
© Decomurale 2025 Tous droits réservés | Kanguru Digital Agency

Il y a 1 articles dans votre panier
Tout (Taxes incl) : $324

